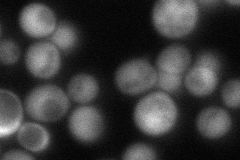
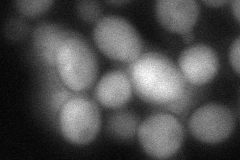

View description
Microtubule-associated protein (MAP) of the XMAP215/Dis1 family; regulates microtubule dynamics during spindle orientation and metaphase chromosome alignment; interacts with spindle pole body component Spc72p
Localization:
Intensity:
Fold change:
Significance:
-
C’ GFP library in SD

punctate35.7 -
N' NOP1pr-GFP in SD

cytosol211.373 -
N' TEF2pr-mCherry in SD

punctate,nucleus372.032 -
N' NATIVEpr-GFP in SD
cytosol82.9491 -
N' TEF2pr-VC and Cyto-VN in SD
cytosol83.5588 -
C’ GFP library in SD+DTT

punctate37.51.05No -
C’ GFP library in SD+H2O2

punctate38.041.06No -
C’ GFP library in Starvation Media

punctate30.790.86No -
C’ GFP library on the background of Pup2-DaMP

punctate -
C’ GFP library on the background of CCT mutant

punctate40.50231.13409No
